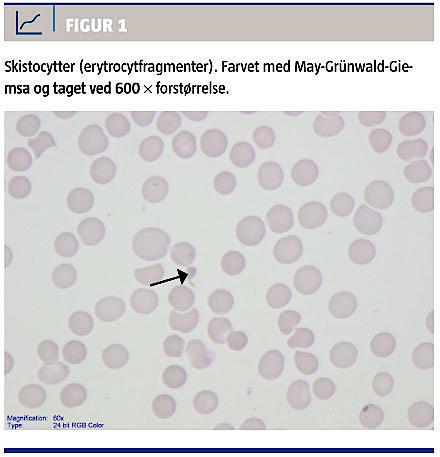

Trombotisk trombocytopenisk purpura (TTP) er et akut syndrom med multiorganpåvirkning, intravaskulær hæmolytisk anæmi og trombocytopeni. Det er en sjælden lidelse, men det er vigtigt at have diagnosen in mente, da det er afgørende for prognosen at få den rette behandling hurtigst muligt. Ubehandlet var der tidligere en mortalitet på op til 90% for TTP, efter indførelse af plasmaferese er den 20% [1].
SYGEHISTORIE
En 14-årig tidligere rask dreng blev indlagt pga. træthed, dyspnø, ikterus, hovedpine og mavesmerter. Ud over hovedpine var der ingen neurologiske symptomer. En uge forinden havde han været ude at spise
og fik efterfølgende diarré og opkastninger i to dage. Ved ankomst til hospitalet fandt man flg. niveauer i blodprøverne: hæmoglobin 3,7 mmol/l, trombocytter (trc) 14 × 109/l, leucocytter 4,9 × 109/l, reticulocytter 329 × 109/l (normalværdi: 37-106 × 109/l), laktatdehydrogenase 829 E/l (normalværdi: 100-345 E/l),
bilirubin 49 mikromol/l (normalværdi: 5-25 mikromol/l) og normale nyretal. Videre udredning viste negativ Coombs test og perifert udstryg med 2-4% skistocytter (Figur 1). Ved en UL-skanning af abdomen fandt man let splenomegali og ellers normale forhold. En røntgenoptagelse af thorax viste normale forhold. Afføringsprøver viste vækst af
Campylobacter jejuni og Salmonella szentes. En
knoglemarvsundersøgelse på syvendedagen viste øget erytropoiese og mange megakaryocytter. ADAMTS13-test blev taget på den første indlæggelsesdag, og endeligt svar, der fremkom på dag 7, viste et lavt ADAMTS-proteinniveau på < 0,04 arb.enh/l (normalværdi: 0,75-1,33 arb.enh/l) og positivt testresultat for autoantistoffer. Pga. af skistocytterne havde man mistanke om diagnosen TTP fra den første dag. Da der var fravær af nyresymptomer og neurologiske symptomer, forsøgte man uden sufficient effekt initial behandling med frisk frosset plasma i fem dage. Derfor blev der på den sjette indlæggelsesdag påbegyndt plasmaferese, initialt i fem døgn, og trc-niveauet steg til 63 × 109/l (Figur 2). Efter fire dages pause faldt trc-niveauet til 14 × 109/l, og plasmaferesen blev genoptaget og suppleret med prednisolon. Denne gang gav man plasmaferese i 17 dage. To uger efter første plasmaferese påbegyndte man pga. kun partiel respons behandling med rituximab 375 mg/m2× 1 ugentligt i fire uger. Trc-niveauet steg på denne behandling til 185 × 109/l. Desværre fik patienten recidiv efter to døgns pause fra plasmaferesen pga. norovirusinfektion. Der blev atter givet plasmaferese i fem dage, og trc-niveauet steg fra 10 til 153 × 109/l. Prednisolon blev udtrappet over en måned.
Et år efter afsluttet behandling var hæmatologien stabil med normalt hæmoglobin- og trc-niveau, og drengen var i velbefindende. ADAMTS13-niveauet var i efterforløbet lav eller lavt i normalområdet, og der var derfor øget risiko for recidiv. Han blev fortsat fulgt ambulant og skulle ses akut, hvis der opstod symptomer.

DISKUSSION
Diagnosen TTP stilles ved trombocytopeni, intravaskulær hæmolytisk anæmi (højt bilirubin- og forhøjet laktatdehydrogenaseniveau), negativ Coombs test, skistocytose i perifert blod samt normale/nær normale koagulationsparametre. Patienter med klassisk TTP har typisk ingen eller minimale neurologiske symptomer og nyrepåvirkning [2]. Til sammenligning ses der typisk hos børn med hæmolytisk uræmisk syndrom nyrepåvirkning ud over intravaskulær hæmolytisk anæmi og trombocytopeni [2]. Hæmolytisk uræmisk syndrom er ikke en lige så alvorlig tilstand som TTP og kræver ikke nødvendigvis plasmaferese som en del af behandlingen [2].
ADAMTS13, også kaldet von Willebrand factor cleaving protease, er et enzym, der spalter von Wille-brand faktor. Patienter med lavt niveau af ADAMTS- 13 ved diagnosetidspunktet, som patienten i syge-
historien, har højere risiko for recidiv end andre. Tilsvarende ses der sjældent recidiv, når der ikke er ADAMTS13-mangel [2, 3]. Test for ADAMTS13 er ikke diagnostisk, og man skal ikke afvente resultatet, før man påbegynder behandling, da udsættelse af behandling med plasmaferese kan have alvorlige konsekvenser for prognosen [4].
Man skelner mellem hereditær og erhvervet TTP. Hereditær TTP er sjælden og er associeret med lavt ADAMTS13-niveau og ingen autoantistoffer. Er-hvervet TTP kan være idiopatisk og associeret med autoantistoffer og lavt ADAMTS13-niveau eller
sekundær til en række forskellige tilstande og sygdomme, heriblandt graviditet, madforgiftning
(hyppigst E. coli 0157:H7), brug af lægemidler, dissemineret cancer, allogen stamcelletransplantation, autoimmun sygdom og infektion [2, 5]. Patienten i sygehistorien havde lavt ADAMTS13-niveau og positive autoantistoffer og således en erhvervet TTP, formentlig efter en tarminfektion.
Sygehistorien understreger, at diagnosen TTP
er vigtig at overveje ved trombocytopeni og hæmolyse, så behandling med plasmaferese kan i værksættes. Plasmaferesebehandling kan være nødvendig i længere tid, og det kan være nødvendigt at supplere med prednisolon og rituximab. Herudover skal ADAMTS13-niveauet kontrolleres for at vurdere risikoen for recidiv.
Korrespondance: Katrine Bredsdorff Spangenberg, BørneUngeklinikken,
Juliane Marie Centret, Rigshospitalet, Blegdamsvej 9, 2100 København Ø.
E-mail: katrinebs@gmail.com
Antaget: 20. maj 2014
Publiceret på Ugeskriftet.dk: 18. august 2014
Interessekonflikter:
<h2>LITTERATUR</h2>
<ol type="d">
<li><p>Deford CC, Reese JA, Schwartz LH et al. Multiple major morbidities and increased mortality during long-term follow-up after recovery from thrombotic thrombo-<br>cytopenic purpura. Blood 2013;122:2023-9.</p></li>
<li><p>George JN. How I treat patients with thrombotic thrombocytopenic purpura: 2010. Blood 2010;116:4060.</p></li>
<li><p>Sadler JE, Moake JL, Miyata T et al. Recent advances in thombotic thrombocytopenic ourpura. Hematology AM Soc Hematol Educ Program 2004:407-23. </p></li>
<li><p>Reese JA, Muthurajah DS, Hovinga JAK et al. Children and adults with thrombotic thrombocytopenic purpura associated with severe acquired Adamts13 Deficiency: comparison of incidence, demographic and clinical features. Pediatr Blood Cancer 2013;60:1676-80.</p></li>
<li><p>Loirat C, Coppo P, Veyradier A. Thrombotic thrombocytopenic pupura in children. Curr Opin Pediatr 2013;25:216-24. </p></li>
</ol>
Thrombotic thrombocytopenic purpura (TTP) is a rare condition, but important to consider in case of thrombocytopenia and haemolysis. It is imperative to proceed with the correct treatment, in order to ensure a satisfactory outcome. TTP is either acquired or idiopathic. This case report shows that a 14-year-old boy has acquired TTP due to an infection with Campylobacter jejuni and Samonella szentes. Plasma exchange plays an essential role in the treatment of TTP.